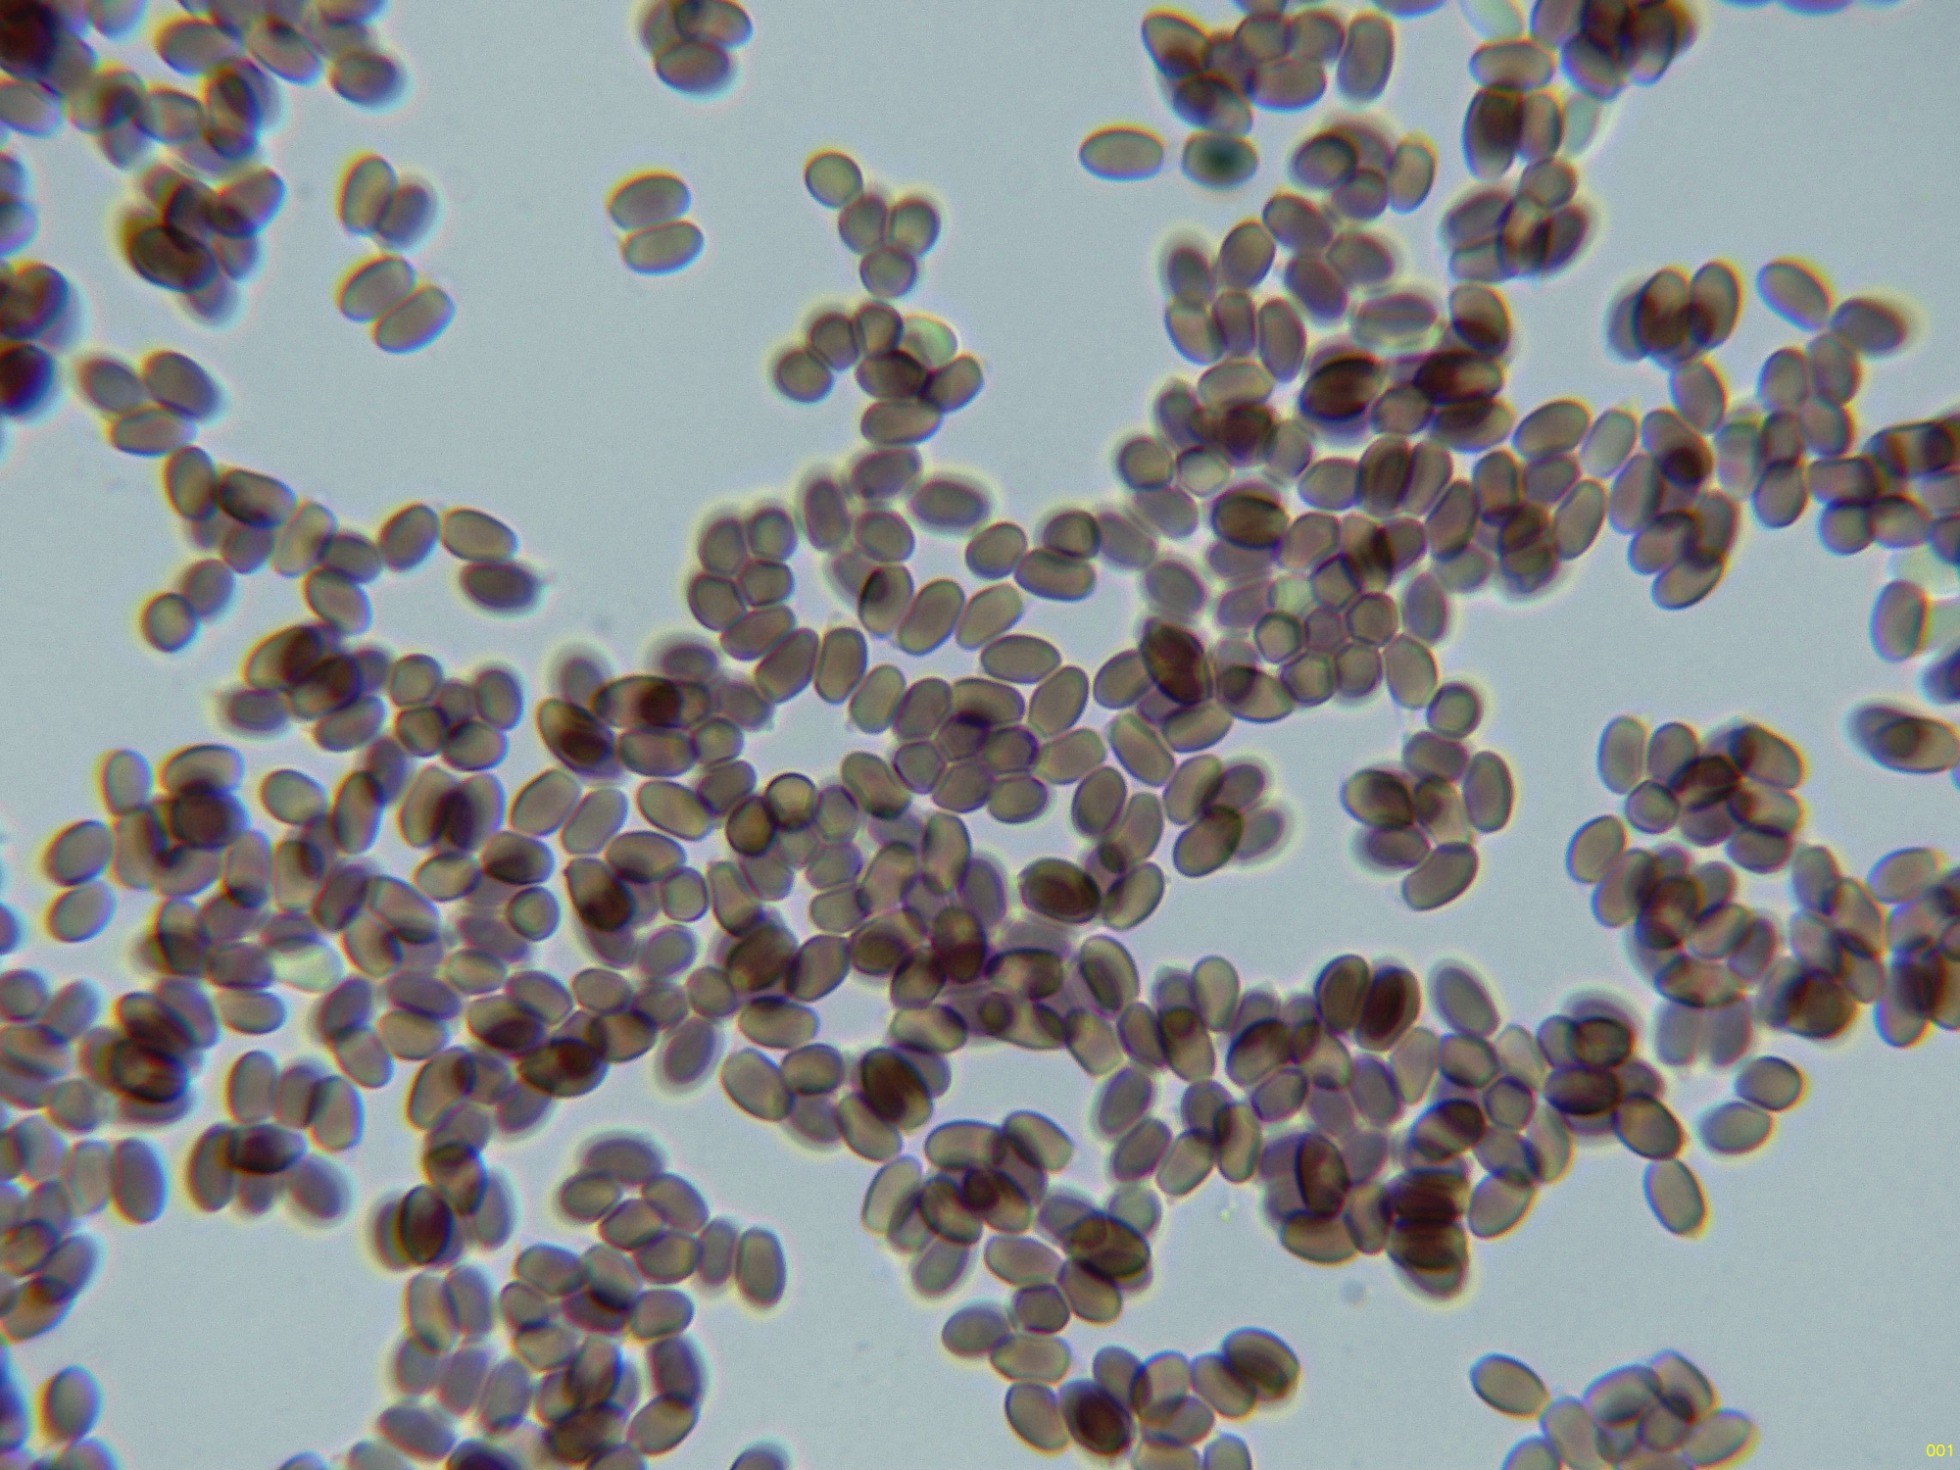
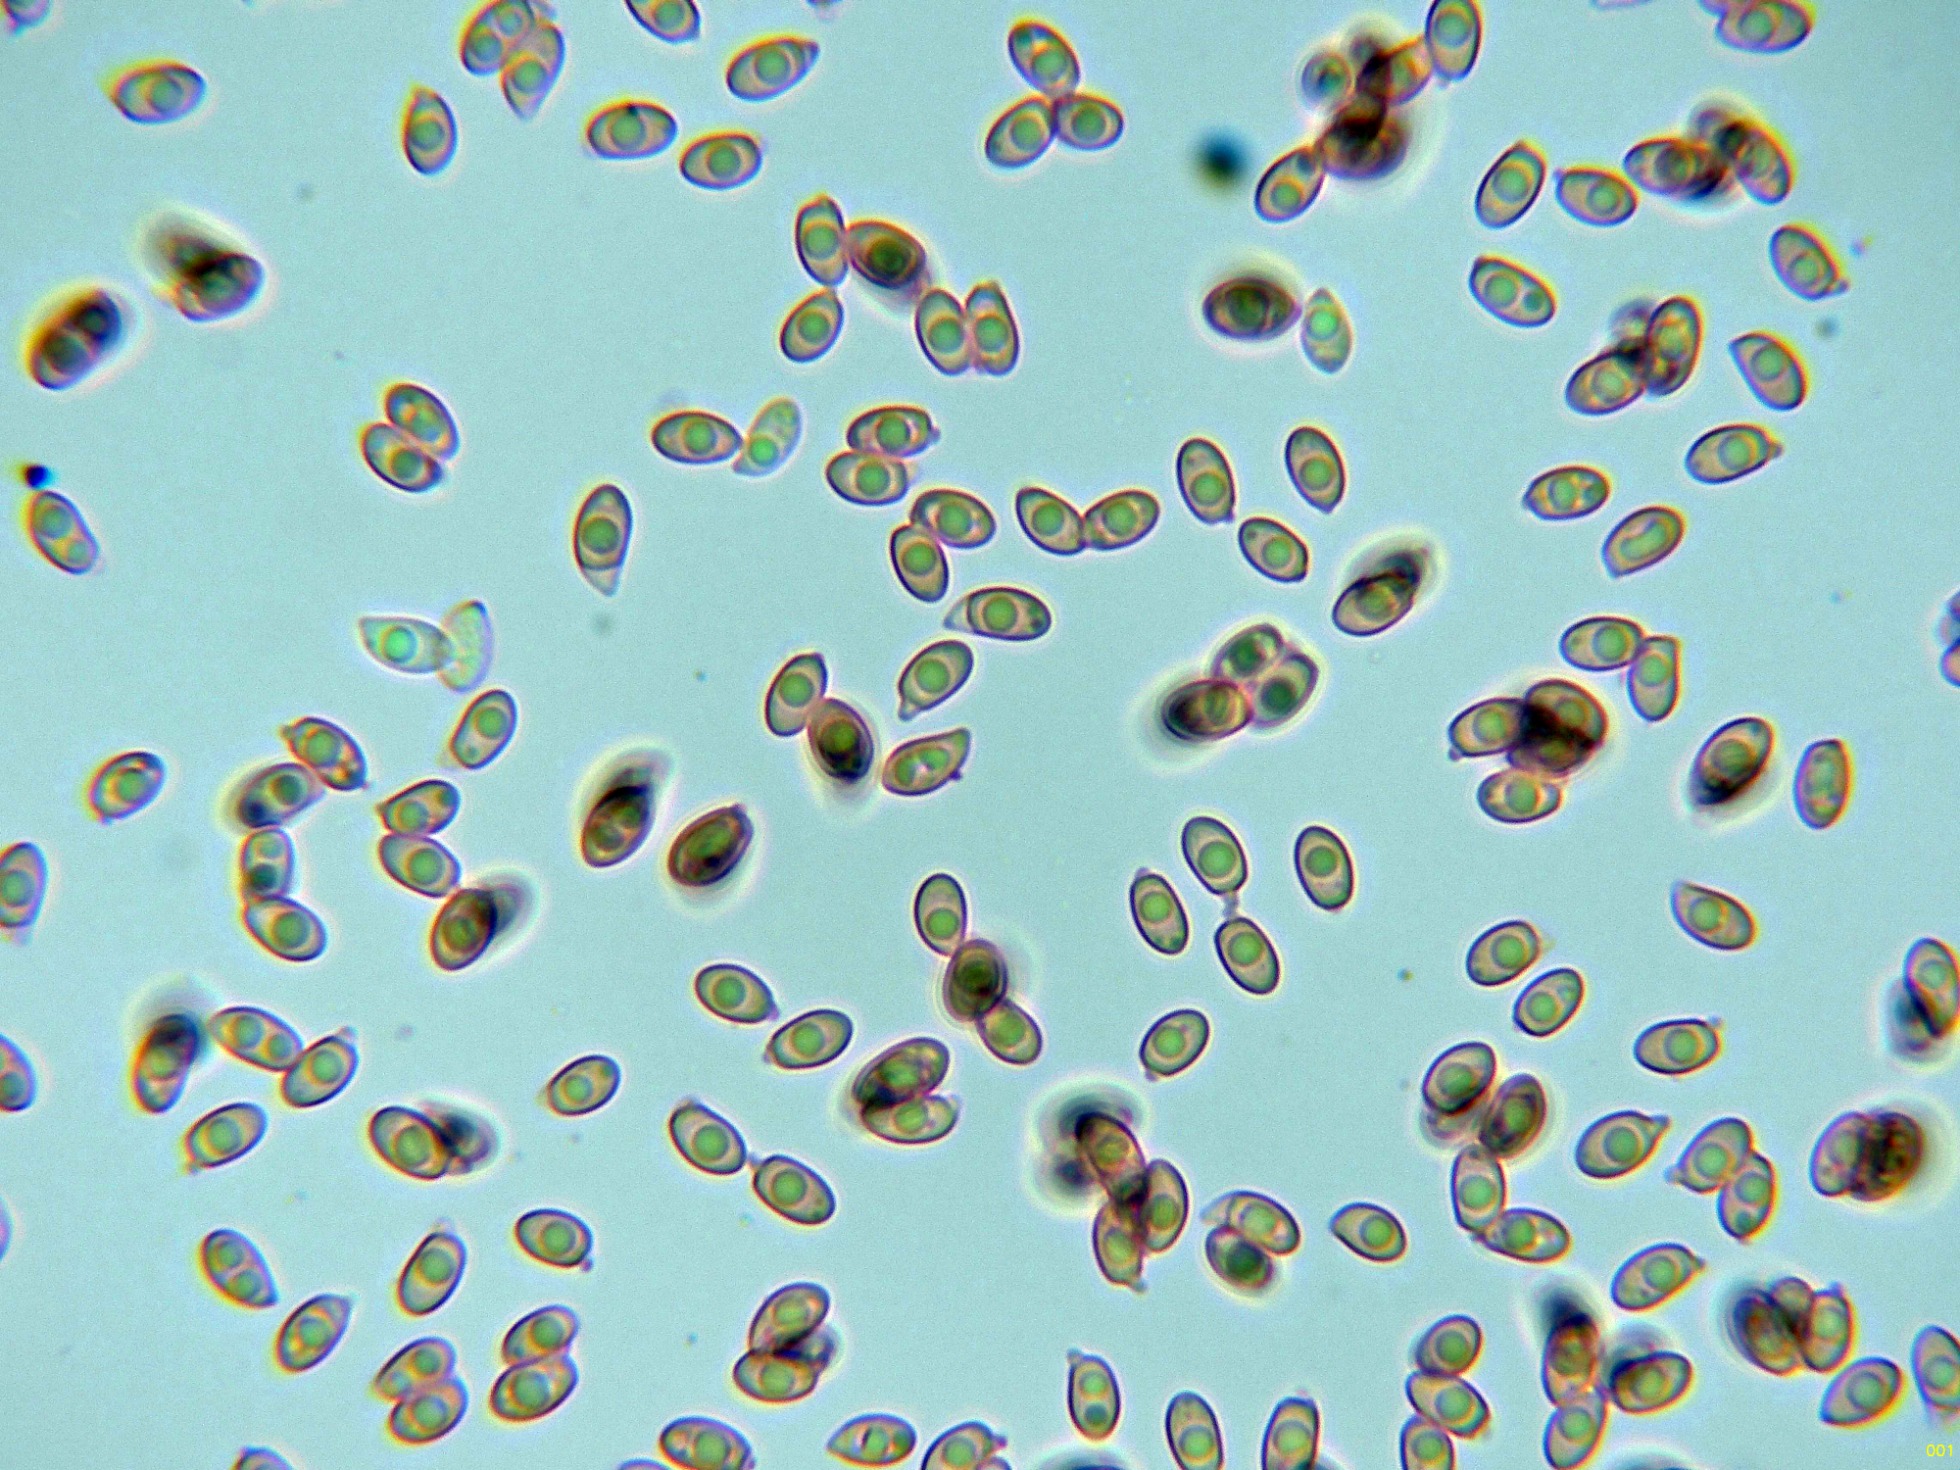

Un resto del 27 de octubre pasado.
Un resto del 27 de octubre pasado.
- Josep Torres
-
 Autor del tema
Autor del tema
- Ausente
- Moderador
-

Menos
Más
- Mensajes: 8746
- Gracias recibidas: 8379
1 año 5 meses antes - 1 año 5 meses antes #110313
por Josep Torres
Un resto del 27 de octubre pasado. Publicado por Josep Torres
Hola a tod@s.
El resto de la salida del domingo 27 de octubre, todo de especies que ya había estudiado con anterioridad.
El primero un Coccomyces, hasta ahora solo lo había encontrado sobre hojas de roble, ahora también sobre una pequeña hoja en descomposición de Rhamnus alaternus, el Coccomyces dentatus.
Los ascomas a 40 aumentos:
Las hifas del excípulo en agua:
Los ascos en agua:
Y por último las paráfisis en agua:
Un Entoloma de los azules, todo apunta al Entoloma mougeotii.
Las hifas de la suprapellis en agua, fuertemente pigmentadas:
Hifas de la subpellis ya más hialinas:
Caulocistidios de la parte alta del pie a 400 aumentos:
Arista laminar en solución de rojo Congo:
Arista laminar en amoníaco:
Los basidios de la cara laminar en Rojo Congo:
Los basidios de la cara laminar en amoníaco:
Detalle de la base de los basidios sin fíbulas:
Las esporas en agua:
Estas esporas obtenidas por esporulación natural y en agua con unas medidas de:
(8.4) 9 - 11.3 (11.8) × (6) 6.2 - 7.2 (7.8) µm
Q = (1.3) 1.4 - 1.6 (1.8) ; N = 40
Me = 10.2 × 6.7 µm ; Qe = 1.5
Sobre excrementos de ganado vacuno tenemos el Panaeolus papilionaceus.
Las hifas de la cutícula celulósica en agua:
Los queilocistidios:
Los basidios:
Y las esporas libres:
Estas esporas libres con unas medidas de:
(13.5) 14.2 - 16.1 (16.6) × (7.9) 8.8 - 10.7 (11.3) µm
Q = (1.4) 1.44 - 1.6 (1.7) ; N = 20
Me = 15.2 × 10 µm ; Qe = 1.5
Muy abundante, conocida coloquialmente como la butifarra, la Rhodocollybia butyracea.
Las esporas en Reactivo de Melzer, con reacción dextrinoide:
Las esporas en solución de Rojo Congo:
Estas esporas con unas medidas de:
(5.7) 5.8 - 6.6 (6.9) × (3.1) 3.4 - 3.9 (4) µm
Q = (1.6) 1.61 - 1.9 (2) ; N = 30
Me = 6.3 × 3.6 µm ; Qe = 1.7
Y ya sin microscopía, tenemos por un lado una buena flota de la mortal Galerina marginata.
Para terminar un par de imágenes de la Amanita ovoidea.
Y como no solo de micología vive el hombre, una imágen de la cestica de la recogida para la cocina, con un puñado de las tan codiciadas en mi Comunidad "llenegas" (Hygrophorus latitabundus)
Saludos a tod@s.
El resto de la salida del domingo 27 de octubre, todo de especies que ya había estudiado con anterioridad.
El primero un Coccomyces, hasta ahora solo lo había encontrado sobre hojas de roble, ahora también sobre una pequeña hoja en descomposición de Rhamnus alaternus, el Coccomyces dentatus.
Los ascomas a 40 aumentos:
Las hifas del excípulo en agua:
Los ascos en agua:
Y por último las paráfisis en agua:
Un Entoloma de los azules, todo apunta al Entoloma mougeotii.
Las hifas de la suprapellis en agua, fuertemente pigmentadas:
Hifas de la subpellis ya más hialinas:
Caulocistidios de la parte alta del pie a 400 aumentos:
Arista laminar en solución de rojo Congo:
Arista laminar en amoníaco:
Los basidios de la cara laminar en Rojo Congo:
Los basidios de la cara laminar en amoníaco:
Detalle de la base de los basidios sin fíbulas:
Las esporas en agua:
Estas esporas obtenidas por esporulación natural y en agua con unas medidas de:
(8.4) 9 - 11.3 (11.8) × (6) 6.2 - 7.2 (7.8) µm
Q = (1.3) 1.4 - 1.6 (1.8) ; N = 40
Me = 10.2 × 6.7 µm ; Qe = 1.5
Sobre excrementos de ganado vacuno tenemos el Panaeolus papilionaceus.
Las hifas de la cutícula celulósica en agua:
Los queilocistidios:
Los basidios:
Y las esporas libres:
Estas esporas libres con unas medidas de:
(13.5) 14.2 - 16.1 (16.6) × (7.9) 8.8 - 10.7 (11.3) µm
Q = (1.4) 1.44 - 1.6 (1.7) ; N = 20
Me = 15.2 × 10 µm ; Qe = 1.5
Muy abundante, conocida coloquialmente como la butifarra, la Rhodocollybia butyracea.
Las esporas en Reactivo de Melzer, con reacción dextrinoide:
Las esporas en solución de Rojo Congo:
Estas esporas con unas medidas de:
(5.7) 5.8 - 6.6 (6.9) × (3.1) 3.4 - 3.9 (4) µm
Q = (1.6) 1.61 - 1.9 (2) ; N = 30
Me = 6.3 × 3.6 µm ; Qe = 1.7
Y ya sin microscopía, tenemos por un lado una buena flota de la mortal Galerina marginata.
Para terminar un par de imágenes de la Amanita ovoidea.
Y como no solo de micología vive el hombre, una imágen de la cestica de la recogida para la cocina, con un puñado de las tan codiciadas en mi Comunidad "llenegas" (Hygrophorus latitabundus)
Saludos a tod@s.
Adjuntos:
Última Edición: 1 año 5 meses antes por Josep Torres. Razón: Editar un salto de línea
El siguiente usuario dijo gracias: Juan Andrés Román
Por favor, Identificarse para unirse a la conversación.
Tiempo de carga de la página: 0.411 segundos

Foro de micología